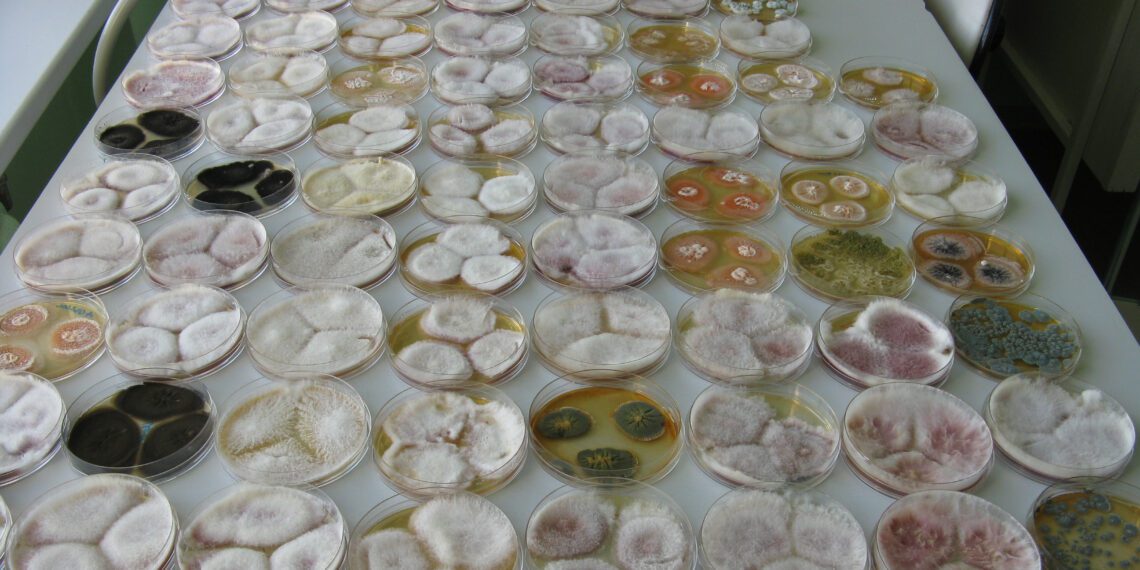
Saastumise riski määramine METK Saku laboris.

Käesolev taimekasvatushooaeg on pakkunud põllumeestele mitmeid väljakutseid sagedaste ja rohkete vihmade tõttu. Nii tali- kui ka suviteraviljad sattusid õitsema vihmaperioodil, mis soodustas mullas elavate hallitusseente levikut peadesse ja pähikutesse. Koristusaegsed vihmad suurendasid nakatumise riski veelgi.
Hallitusseente loomulik roll mullas on orgaanilise aine lagundamine. Taimede ja terade pinnal elavad endofüütsed mikroseened ei kujuta kuivas ja stabiilses keskkonnas vilja kvaliteedile ohtu. Probleemid tekivad aga siis, kui keskkonnas valitsevad äärmuslikud tingimused – näiteks liigniiskus või suured temperatuuride kõikumised. Sellistes oludes hakkavad mitmed mikro- ja hallitusseened aktiivselt kasvama ning eoseid levitama. See väljendub teraviljadel näiteks peade tumenemises Alternaria seente levikuga või roosakas kuni helepruuni seeneniidistiku tekkes fusarioosi puhul, mida põhjustavad Fusarium seened.
Koristusjärgselt soodustab mikro-ja hallitusseente kasvu kõrge terade niiskus ja viljakuhila soojenemine. Esimeseks ohumärgiks vilja mikrobioloogilise kvaliteedi halvenemisest ongi hallitusseente nähtav kasv teradel.
Mükotoksiinid – nähtamatu oht
Lisaks hallitusseentele mõjutab vilja kvaliteeti ka toksikoloogiline saaste ehk mükotoksiinide sisaldus. Need on keemilised ühendid, mis tekivad seente elutegevuse käigus. Mükotoksiine teradest enam eemaldada ei ole võimalik. Söödavilja puhul saab küll kasutada mükotoksiinisidujad, kuid see ei asenda ennetavaid meetmeid.
Viljaterminalides kontrollitakse tavaliselt deoksünivalenooli (DON, tuntud ka kui vomitoksiin) sisaldust. Tegelikkuses võib vili saastuda ka teiste toksiinidega: DONi derivaatidega, samuti zearalenooni (ZEN), ohratoksiini (OTA), alternarioolide ja teiste ühenditega. Nendega seoses on pistelist kontrolli läbi viinud Põllumajandus- ja Toiduamet, kuid kokkuostjad neid üldjuhul ei analüüsi.
Seos ilmastiku ja taimekaitsega
Uuringud on näidanud, et vihmasel kasvuperioodil ja koristusajal võib teraviljade õitsemise ajal tehtud fungitsiiditõrje vähendada hallitusseente levikut. Mükotoksiinide tekke riski vähendas mitme toimeainega fungitsiid, samas kui ühe toimeaine kasutamine seda vältida ei suutnud.
Mida saab saastumise ärahoidmiseks veel teha?
- Koristuse järel: saastunud teri saab vähendada kohese sorteerimise ja kuivatamisega.
- Ladustamisel: hoida vilja stabiilses, kuivas ja jahedas keskkonnas.
- Rohusöötade puhul: silo valmistamisel kasutada silokonservante ning tagada õhukindel sulgemine, sest hallitusseened ja mükotoksiinid tekivad eelkõige hapniku juuresolekul.
- Kontroll: sellel aastal on eriti oluline regulaarselt jälgida nii ladustatava vilja kui ka söötade hallitusseente ja mükotoksiinide sisaldust.
METK Saku laboris on võimalik määrata nii mükotoksiinide (DON ja OTA) sisaldust, kui ka hallitus- ja pärmseente üldarvukust ning spetsiifiliste seenhaiguste sh fusaariumite ja alternaariate olemasolu proovis.
Lisainfo: metk.agri.ee